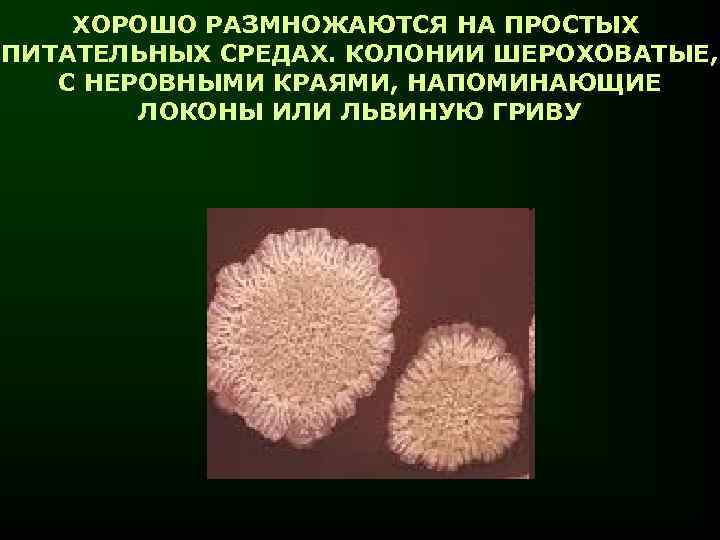
ХОРОШО РАЗМНОЖАЮТСЯ НА ПРОСТЫХ ПИТАТЕЛЬНЫХ СРЕДАХ. КОЛОНИИ ШЕРОХОВАТЫЕ, С НЕРОВНЫМИ КРАЯМИ, НАПОМИНАЮЩИЕ ЛОКОНЫ ИЛИ
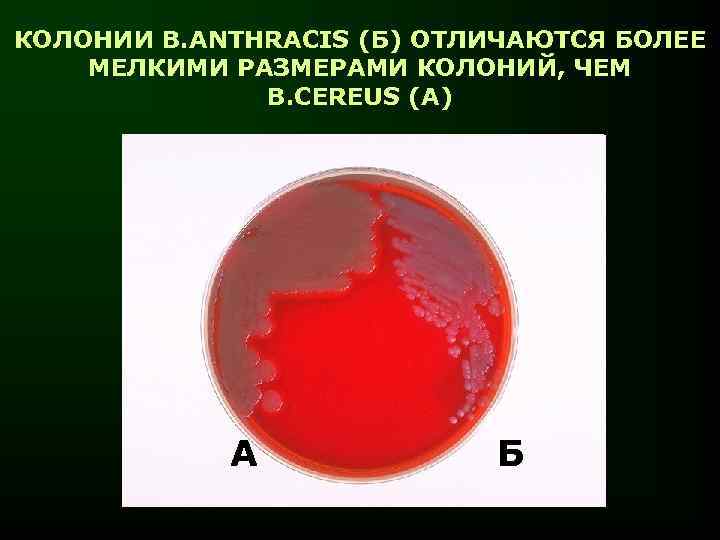
КОЛОНИИ B. ANTHRACIS (Б) ОТЛИЧАЮТСЯ БОЛЕЕ МЕЛКИМИ РАЗМЕРАМИ КОЛОНИЙ, ЧЕМ B. CEREUS (А) А

Курс лекций - коринебактерии, бациллы.ppt
- Количество слайдов: 40

ЛЕКЦИЯ ГРАМПОЛОЖИТЕЛЬНЫЕ АЭРОБНЫЕ ПАЛОЧКИ. КОРИНЕБАКТЕРИИ. БАЦИЛЛЫ. ОБЩАЯ ХАРАКТЕРИСТИКА. ЗНАЧЕНИЕ В ПАТОЛОГИИ ЧЕЛОВЕКА.

СИСТЕМАТИКА ТАКСОНОМИЧЕСКИ НЕОПРЕДЕЛЁННАЯ ГРУППА РОД ВИДЫ CORYNEBACTERIUM C. DIPHTHERIAE, C. PSEUDODIPHTHERITICUM, C. XEROSIS

ОБЩАЯ ХАРАКТЕРИСТИКА Грам + ПАЛОЧКИ, ДЛИНОЙ 1 – 8 мкм. В МИКРОСКОПИЧЕСКИХ ПРЕПАРАТАХ РАСПОЛАГАЮТСЯ ПОД УГЛОМ ДРУГ К ДРУГУ. ПО КОНЦАМ ИМЕЮТСЯ УТОЛЩЕНИЯ, ОБУСЛОВЛЕННЫЕ НАЛИЧИЕМ ЗЁРЕН ВОЛЮТИНА ОБРАЗУЮТ МИКРОКАПСУЛУ. НЕПОДВИЖНЫ. ХЕМООРГАНОТРОФЫ. ФАКУЛЬТАТИВНЫЕ АНАЭРОБЫ.

С. DIPHTHERIAE В МАЗКЕ ИЗ ЗЕВА, ОКРАСКА ПО ГРАМУ

С. DIPHTHERIAE В ЧИСТОЙ КУЛЬТУРЕ, ОКРАСКА ПО ЛЕФФЛЕРУ

В СОСТАВ КЛЕТОЧНОЙ СТЕНКИ КОРИНЕБАКТЕРИЙ ВХОДЯТ СПЕЦИФИЧНЫЕ ТОЛЬКО ДЛЯ НИХ ЛИПИДЫ: ЭФИРЫ КОРИНЕМИКОЛОВОЙ И КОРИНЕМИКОЛИНОВОЙ КИСЛОТ и др.

КОРИНЕБАКТЕРИИ ТРЕБОВАТЕЛЬНЫ К ПИТАТЕЛЬНЫМ СРЕДАМ: НУЖДАЮТСЯ ПОЧТИ ВО ВСЕХ АМИНОКИСЛОТАХ, МИКРОЭЛЕМЕНТАХ КОРИНЕБАКТЕРИИ КУЛЬТИВИРУЮТ НА СРЕДАХ С ДОБАВЛЕНИЕМ СЫВОРОТКИ КРОВИ, А ТАКЖЕ ТЕЛЛУРИТОВОМ АГАРЕ

РОСТ КОЛОНИЙ КОРИНЕБАКТЕРИИ ДИФТЕРИИ НА ТЕЛЛУРИТОВОМ АГАРЕ

ПО МОРФОЛОГИИ КОЛОНИЙ, ХАРАКТЕРУ РОСТА НА ТЕЛЛУРИТОВОМ АГАРЕ, ФЕРМЕНТАТИВНОЙ АКТИВНОСТИ, ГЕМОЛИТИЧЕСКИМ СВОЙСТВАМ КОРИНЕБАКТЕРИИ ДИФТЕРИИ РАЗДЕЛЯЮТ НА ТРИ ГРУППЫ (БИОВАРА) • GRAVIS, • MITIS, • INTERMEDIUM

КОЛОНИИ КОРИНЕБАКТЕРИИ ДИФТЕРИИ НА КРОВЯНОМ АГАРЕ: СЛЕВА – БИОВАР MITIS, СПРАВА - GRAVIS

АНТИГЕНЫ (МИКРОКАПСУЛА, ПОЛИСАХАРИД КЛЕТОЧНОЙ СТЕНКИ) ДИФФЕРЕНЦИРОВОЧНОГО ЗНАЧЕНИЯ НЕ ИМЕЮТ

ЧУВСТВИТЕЛЬНОСТЬ КОРИНЕБАКТЕРИИ ДИФТЕРИИ К ДЕЙСТВИЮ ФИЗИКО-ХИМИЧЕСКИХ ФАКТОРОВ ХОРОШО ПЕРЕНОСЯТ ВЫСУШИВАНИЕ. В ПЫЛИ СОХРАНЯЮТ ЖИЗНЕСПОСОБНОСТЬ В ТЕЧЕНИЕ 5 МЕСЯЦЕВ В ТЕЧЕНИЕ НЕСКОЛЬКИХ ДНЕЙ СОХРАНЯЮТСЯ НА ПОСУДЕ, ИГРУШКАХ, ПРЕДМЕТАХ ОБИХОДА ВЫСОКО ЧУВСТВИТЕЛЬНЫ К ДЕЗИНФЕКТАНТАМ

ФАКТОРЫ ПАТОГЕННОСТИ ВОЗБУДИТЕЛЯ ДИФТЕРИИ ФИМБРИИ МИКРОКАПСУЛА ГИАЛУРОНИДАЗА, НЕЙРАМИНИДАЗА, ФИБРИНОЛИЗИН КОРД-ФАКТОР (ДИМИКОЛАТ ТРЕГАЛОЗЫ) НАРУШАЕТ ФОСФОРИЛИРОВАНИЕ И ДЫХАНИЕ КЛЕТОК ОРГАНИЗМА-ХОЗЯИНА

ДИФТЕРИЙНЫЙ ГИСТОТОКСИН ДЕТЕРМИНИРУЕТСЯ ТРАНСДУЦИРУЮЩИМ БАКТЕРИОФАГОМ, ОБЛАДАЕТ ШИРОКИМ ЦИТОТРОПИЗМОМ ФРАГМЕНТ В ОТВЕЧАЕТ ЗА ВЗАИМОДЕЙСТВИЕ МОЛЕКУЛЫ С ЧУВСТВИТЕЛЬНОЙ КЛЕТКОЙ. ФРАГМЕНТ А ИНАКТИВИРУЕТ ТРАНСЛОКАЦИЮ В РЕЗУЛЬТАТЕ БЛОКАДЫ ФАКТОРА ЭЛОНГАЦИИ 2 НЕКРОЗ КЛЕТКИ. ПРОИСХОДИТ СНИЖЕНИЕ СКОРОСТИ ОКИСЛЕНИЯ ЖИРНЫХ КИСЛОТ С ДЛИННОЙ ЦЕПЬЮ, ПРИ НАРУШЕНИИ МЕТАБОЛИЗМА КАРНИТИНА ЖИРОВАЯ ДЕГЕНЕРАЦИЯ КАРДИОМИОЦИТОВ.

ФИЛЬТР, ПРОПИТАННЫЙ АНТИТОКСИНОМ (АНТИТЕЛАМИ КЭКЗОТОКСИНУ) РОСТ АТОКСИГЕННОГО ШТАММА (- КОНТРОЛЬ) ИССЛЕДУЕМАЯ КУЛЬТУРА КОРИНЕБАКТЕРИЙ РОСТ ТОКСИГЕННОГО ШТАММА (+ КОНТРОЛЬ) ЛИНИИ ПРЕЦИПИТАЦИИ ОПРЕДЕЛЕНИЕ ТОКСИГЕННОСТИ КОРИНЕБАКТЕРИЙ

ДИФТЕРИЯ – ЭТО ОСТРОЕ ИНФЕКЦИОННОЕ ЗАБОЛЕВАНИЕ, ВЫЗЫВАЕМОЕ КОРИНЕБАКТЕРИЯМИ ДИФТЕРИИ И ХАРАКТЕРИЗУЮЩЕЕСЯ МЕСТНЫМ ВОСПАЛЕНИЕМ СЛИЗИСТЫХ ОБОЛОЧЕК ВЕРХНИХ ДЫХАТЕЛЬНЫХ ПУТЕЙ, А ТАКЖЕ ТОКСИЧЕСКИМ ПОРАЖЕНИЕМ, СЕРДЦА И ПЕРИФЕРИЧЕСКИХ НЕРВОВ

ФИБРИННЫЕ ПЛЁНКИ ПРИ ДИФТЕРИИ

ОТЁК ПОДКОЖНОЙ КЛЕТЧАТКИ ШЕИ ПРИ ТОКСИЧЕСКОЙ ФОРМЕ ДИФТЕРИИ

ФАКТОРЫ ЗАЩИТЫ ОРГАНИЗМА ОТ КОРИНЕБАКТЕРИЙ НА УРОВНЕ ФИЗИОЛОГИЧЕСКИХ НЕСПЕЦИФИЧЕСКИХ РЕАКЦИЙ ЦЕЛОСТНОСТЬ ПОКРОВНЫХ ТКАНЕЙ ПОТЕНЦИАЛ АУТОМИКРОФЛОРЫ НА УРОВНЕ АНТИГЕНСПЕЦИФИЧЕСКОГО ИММУНИТЕТА - АНТИТЕЛА

ЛЕЧЕНИЕ ДИФТЕРИИ АНТИТОКСИЧЕСКАЯ СЫВОРОТКА АНТИБИОТИКИ

ПРОФИЛАКТИКА ДИФТЕРИИ НЕСПЕЦИФИЧЕСКАЯ ДИФТЕРИЙНЫЙ АНАТОКСИН (АД) ИЗОЛИРОВАННЫЙ ИЛИ В СОСТАВЕ ДРУГИХ ВАКЦИН (АКДС, АДС)

ДИАГНОСТИКА ДИФТЕРИИ МИКРОБИОЛОГИЧЕСКАЯ С ОПРЕДЕЛЕНИЕМ ТОКСИГЕННЫХ СВОЙСТВ КУЛЬТУРЫ СЕРОЛОГИЧЕСКАЯ – ПО ОБНАРУЖЕНИЮ АНТИТЕЛ К ДИФТЕРИЙНОМУ ЭКЗОТОКСИНУ В СЫВОРОТКЕ КРОВИ ПАЦИЕНТА

СИСТЕМАТИКА СЕМЕЙСТВО РОД ВИДЫ BACILLACEAE BACILLUS, CLOSTRIDIUM B. ANTHRACIS, B. CEREUS, B. SUBTILIS

ОБЩАЯ ХАРАКТЕРИСТИКА Грам + КРУПНЫЕ НЕПОДВИЖНЫЕ ПАЛОЧКИ. ХЕМООРГАНОТРОФЫ. АЭРОБЫ ИЛИ ФАКУЛЬТАТИВНЫЕ АНАЭРОБЫ. В МИКРОСКОПИЧЕСКИХ ПРЕПАРАТАХ РАСПОЛАГАЮТСЯ ЦЕПОЧКОЙ (СТРЕПТОБАЦИЛЛЫ).

ЧИСТАЯ КУЛЬТУРА B. ANTHRACIS, ОКРАСКА ПО ГРАМУ

B. ANTHRACIS, СКАНИРУЮЩАЯ ЭЛЕКТРОННАЯ МИКРОСКОПИЯ

ВНЕ ОРГАНИЗМА В ПРИСУТСТВИИ КИСЛОРОДА ОБРАЗУЮТ СПОРЫ, РАСПОЛОЖЕННЫЕ ЦЕНТРАЛЬНО. СПОРЫ B. ANTHRACIS, ОКРАСКА ПО ГРАМУ

СПОРЫ B. ANTHRACIS, СКАНИРУЮЩАЯ ЭЛЕКТРОННАЯ МИКРОСКОПИЯ

В ОРГАНИЗМЕ ЧЕЛОВЕКА И ЖИВОТНЫХ ОБРАЗУЮТ КАПСУЛУ. КАПСУЛА B. ANTHRACIS, ФЛУОРЕСЦЕНТНАЯ МИКРОСКОПИЯ
ХОРОШО РАЗМНОЖАЮТСЯ НА ПРОСТЫХ ПИТАТЕЛЬНЫХ СРЕДАХ. КОЛОНИИ ШЕРОХОВАТЫЕ, С НЕРОВНЫМИ КРАЯМИ, НАПОМИНАЮЩИЕ ЛОКОНЫ ИЛИ ЛЬВИНУЮ ГРИВУ
КОЛОНИИ B. ANTHRACIS (Б) ОТЛИЧАЮТСЯ БОЛЕЕ МЕЛКИМИ РАЗМЕРАМИ КОЛОНИЙ, ЧЕМ B. CEREUS (А) А Б

ПОСЕВ УКОЛОМ В СТОЛБИК ЖЕЛАТИНА ВЫЯВЛЯЕТ РОСТ В ВИДЕ ОПРОКИНУТОЙ «ЁЛОЧКИ» (ВЫЯВЛЕНИЕ НПОДВИЖНОСТИ БАЦИЛЛ)

ДИФФЕРЕНЦИРОВКУ БАЦИЛЛ ПРОВОДЯТ ПО МОРФОЛОГИЧЕСКИМ, ТИНКТОРИАЛЬНЫМ СВОЙСТВАМ, ВЫЯВЛЕНИЮ КАПСУЛЫ, БИОХИМИЧЕСКОЙ АКТИВНОСТИ, ФЕНОМЕНУ «ЖЕМЧУЖНОГО ОЖЕРЕЛЬЯ» ОБРАЗОВАНИЮ ПРОТОПЛАСТОВ ПРИ РОСТЕ НА СРЕДЕ С ПЕНИЦИЛЛИНОМ, АНТИГЕНАМ (КАПСУЛЬНОМУ БЕЛКОВОМУ И ПОЛИСАХАРИДУ КЛЕТОЧНОЙ СТЕНКИ), ПО ЧУВСТВИТЕЛЬНОСТИ К БАКТЕРИОФАГУ, А ТАКЖЕ ПО ПРОДУКЦИИ ЭКЗОТОКСИНА

ГЛАВНЫЙ ФАКТОР ПАТОГЕННОСТИ БАЦИЛЛ СИБИРСКОЙ ЯЗВЫ - ЭКЗОТОКСИН СОСТОИТ ИЗ ТРЁХ КОМПОНЕНТОВ: • ОТЁЧНЫЙ ФАКТОР – ВЫЗЫВАЕТ УВЕЛИЧЕНИЕ УРОВНЯ ц. АМФ, НАРУШАЯ ВОДНО-ЭЛЕКТРОЛИТНЫЙ БАЛАНС КЛЕТКИ, ЧТО СОПРОВОЖДАЕТСЯ РАЗВИТИЕМ ОТЁКА • ЛЕТАЛЬНЫЙ ФАКТОР – ВЫЗЫВАЕТ НЕКРОЗ КЛЕТКИ • ПРОТЕКТИВНЫЙ АНТИГЕН

РЕАЛИЗАЦИЯ ТОКСИЧЕСКОГО ДЕЙСТВИЯ СИБИРЕЯЗВЕННОГО ТОКСИНА ВОЗМОЖНА ПРИ ПРОНИКНОВЕНИИ ЛЕТАЛЬНОГО И/ИЛИ ОТЁЧНОГО ФАКТОРОВ ВНУТРЬ ЧУВСТВИТЕЛЬНОЙ КЛЕТКИ ЭТО ПРОНИКНОВЕНИЕ ОПРЕДЕЛЯЕТСЯ ДЕЙСТВИЕМ ПРОТЕКТИВНОГО АНТИГЕНА, КОТОРЫЙ ПОЛИМЕРИЗУЕТСЯ С РЕЦЕПТОРАМИ КЛЕТОК, СОЗДАЁТ УСЛОВИЯ ДЛЯ СВЯЗЫВАНИЯ ЛЕТАЛЬНОГО И/ИЛИ ОТЁЧНОГО ФАКТОРОВ И ИХ ТРАНСПОРТА ЧЕРЕЗ ЦПМ В ЦИТОПЛАЗМУ КЛЕТКИ

ДРУГИМ ФАКТОРОМ ПАТОГЕННОСТИ БАЦИЛЛ СИБИРСКОЙ ЯЗВЫ ЯВЛЯЕТСЯ КАПСУЛА, ИНГИБИРУЮЩАЯ ФАГОЦИТОЗ

СИБИРСКАЯ ЯЗВА – ОСОБО ОПАСНАЯ, ОСТРАЯ АНТРОПОЗООНОЗНАЯ ИНФЕКЦИЯ, ХАРАКТЕРИЗУЮЩАЯСЯ ИНТОКСИКАЦИЕЙ, ПРОТЕКАЮЩАЯ В КОЖНОЙ, ЛЕГОЧНОЙ И СЕПТИЧЕСКОЙ ФОРМЕ

СИБИРЕЯЗВЕННЫЙ КАРБУНКУЛ

СИБИРЕЯЗВЕННЫЙ КАРБУНКУЛ И ПРИЗНАКИ ОТЁКА ТКАНЕЙ

СПЕЦИФИЧЕСКАЯ ПРОФИЛАКТИКА СИБИРСКОЙ ЯЗВЫ ВАКЦИНА СТИ – ВЗВЕСЬ СПОР АВИРУЛЕНТНОГО ШТАММА. ИММУНИТЕТ – 1 ГОД ЛЕЧЕНИЕ СИБИРСКОЙ ЯЗВЫ ОСУЩЕСТВЛЯЮТ С ПОМОЩЬЮ АНТИБИОТИКОВ
Курс лекций - коринебактерии, бациллы.ppt